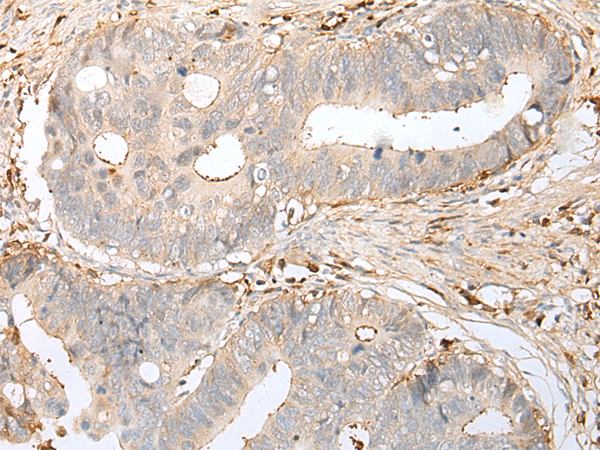
一抗

|
Background: |
This gene encodes a member of the ephrin (EPH) family. The ephrins and EPH-related receptors comprise the largest subfamily of receptor protein-tyrosine kinases and have been implicated in mediating developmental events, especially in the nervous system and in erythropoiesis. Based on their structures and sequence relationships, ephrins are divided into the ephrin-A (EFNA) class, which are anchored to the membrane by a glycosylphosphatidylinositol linkage, and the ephrin-B (EFNB) class, which are transmembrane proteins. This gene encodes an EFNA class ephrin. Three transcript variants that encode distinct proteins have been identified. |
|
Applications: |
ELISA, IHC |
|
Name of antibody: |
EFNA4 |
|
Immunogen: |
Synthetic peptide of human EFNA4 |
|
Full name: |
ephrin-A4 |
|
Synonyms: |
EFL4; EPLG4; LERK4 |
|
SwissProt: |
P52798 |
|
ELISA Recommended dilution: |
5000-10000 |
|
IHC positive control: |
Human cervical cancer and human gastric cancer |
|
IHC Recommend dilution: |
25-100 |


 購物車
購物車 幫助
幫助
 021-54845833/15800441009
021-54845833/15800441009